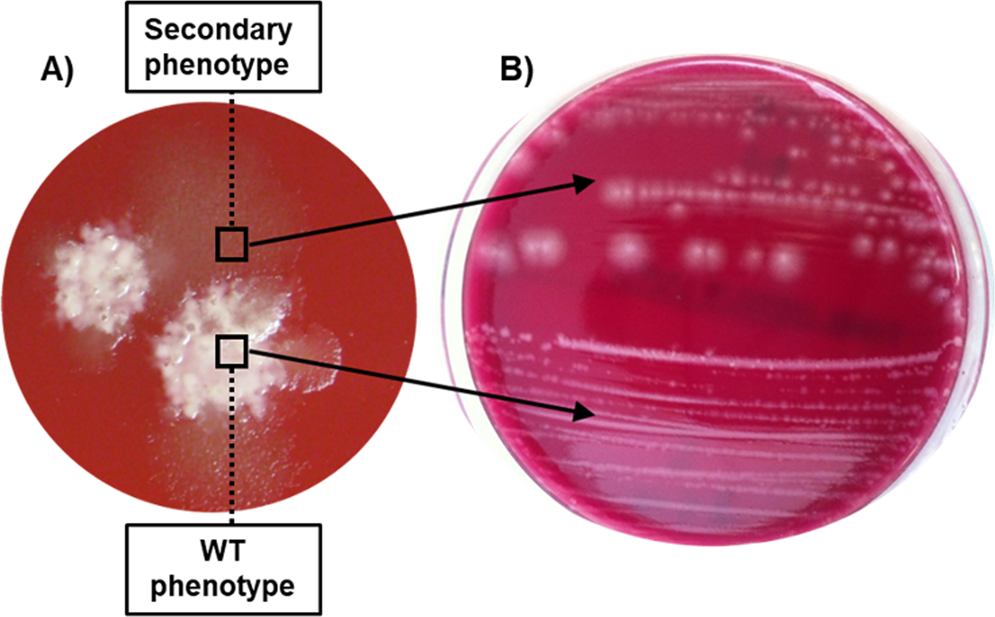

Specimen Collection And Processing Instructions For C Difficile
Specimen Collection And Processing Instructions For C Difficile
 Diagnosis Of C Difficile Why So Difficult Aacc Org
Diagnosis Of C Difficile Why So Difficult Aacc Org
 Specimen Collection 3 Obtaining A Faecal Specimen From A Patient
Specimen Collection 3 Obtaining A Faecal Specimen From A Patient
 Infection Control Ryerson Presentation
Infection Control Ryerson Presentation
 Diagnosis Of C Difficile Why So Difficult Aacc Org
Diagnosis Of C Difficile Why So Difficult Aacc Org
 Two Part Clinical Decision Support Algorithm Note Naat Nucleic
Two Part Clinical Decision Support Algorithm Note Naat Nucleic
 Clostridium Difficile Infection Infectious Disease Advisor
Clostridium Difficile Infection Infectious Disease Advisor
Plos One Gut Microbiota Patterns Associated With Colonization Of
 Laboratory 20 Diagnosis 20of 20gi 20and 20intra Abdominal 20infection
Laboratory 20 Diagnosis 20of 20gi 20and 20intra Abdominal 20infection
 Diagnosis Of C Difficile Why So Difficult Aacc Org
Diagnosis Of C Difficile Why So Difficult Aacc Org
Https Www Myhealthunit Ca En Health Professionals Partners Resources Long Term Care And Retirement Homes C Difficile Pdf
Only Liquid Stools Should Be Sent For C Diff Testing Spectrum
 Comparison Of Routine C Difficile Negative Samples Set Of
Comparison Of Routine C Difficile Negative Samples Set Of
 Ucsf Clinical Laboratories Tests
Ucsf Clinical Laboratories Tests
 Common Questions About Clostridium Difficile Infection American
Common Questions About Clostridium Difficile Infection American
Http Www Ldh La Gov Assets Oph Center Phch Center Ch Infectious Epi Hai Mdro2017 Handouts Commonmdrosinlongtermcare Newest Pdf
 Diagnosis Of C Difficile Why So Difficult Aacc Org
Diagnosis Of C Difficile Why So Difficult Aacc Org
 Drive Cost And Care Improvements With A C Diff Testing Algorithm
Drive Cost And Care Improvements With A C Diff Testing Algorithm
 Common Questions About Clostridium Difficile Infection American
Common Questions About Clostridium Difficile Infection American

 16 Ways To Achieve A Healthy Poop Drjockers Com
16 Ways To Achieve A Healthy Poop Drjockers Com
 Fecal Transplantation For C Difficile A How To Guide
Fecal Transplantation For C Difficile A How To Guide
 Fecal Transplantation For C Difficile A How To Guide
Fecal Transplantation For C Difficile A How To Guide
Clostridium Difficile Two Step Algorithm Testing Spectrum Health
 Understanding Clostridium Difficile Colonization Clinical
Understanding Clostridium Difficile Colonization Clinical
 How You Could Get Paid To Poo Collection Bank Pays 40 A Sample
How You Could Get Paid To Poo Collection Bank Pays 40 A Sample
 Clostridium Difficile Infection Ppt Video Online Download
Clostridium Difficile Infection Ppt Video Online Download
Plos One Gut Microbiota Patterns Associated With Colonization Of
Https Healthinsight Org Tools And Resources Send 33 Webinars 280 Hai Summit Rochelle Neilson Slides
 Syn Lab 2 1 Protects Piglets From Cdi Diarrhea Pilot Non Lethal
Syn Lab 2 1 Protects Piglets From Cdi Diarrhea Pilot Non Lethal
 A Rapid Accurate Single Molecule Counting Method Detects
A Rapid Accurate Single Molecule Counting Method Detects
 Clostridium Difficile Infection Ppt Video Online Download
Clostridium Difficile Infection Ppt Video Online Download
Plos One Gut Microbiota Patterns Associated With Colonization Of
 5 Easy Steps To Prevent C Diff Are You Doing Them
5 Easy Steps To Prevent C Diff Are You Doing Them
 Laboratory Diagnosis Of Clostridium Difficile Insights
Laboratory Diagnosis Of Clostridium Difficile Insights
 Testing Stools For C Diff In Patients After They Have Finished
Testing Stools For C Diff In Patients After They Have Finished
 Faqs For Clinicians About C Diff Cdc
Faqs For Clinicians About C Diff Cdc
 One Minute Guide To Clostridium Difficile Testing Medicine Matters
One Minute Guide To Clostridium Difficile Testing Medicine Matters
Http Www Fha Org Files Hiin Slides 2019 Ip Boot Camp Stewardship For Ips Pdf
 Frontiers Lauric Acid Is An Inhibitor Of Clostridium Difficile
Frontiers Lauric Acid Is An Inhibitor Of Clostridium Difficile
/GettyImages-909208512-5bb9fdedc9e77c00581115ef.jpg) Clostridium Difficile Symptoms And Treatment
Clostridium Difficile Symptoms And Treatment
 Clostridium Difficile Pha Infection Control
Clostridium Difficile Pha Infection Control
 Micro Comments Clostridium Difficile Testing Aimed Let S Talk
Micro Comments Clostridium Difficile Testing Aimed Let S Talk
 How Do You Evaluate And Treat A Patient With C Difficile
How Do You Evaluate And Treat A Patient With C Difficile
 Ppt Clostridium Difficile Infection Powerpoint Presentation
Ppt Clostridium Difficile Infection Powerpoint Presentation
 Routine Stool Culture Looks For Campy Salm Shig E Coli And O157
Routine Stool Culture Looks For Campy Salm Shig E Coli And O157
C Difficile Deadly Diarrhea What You Need To Know Pharmscript
 Medical Sciences Free Full Text Effectiveness Of A Two Step
Medical Sciences Free Full Text Effectiveness Of A Two Step
Https Www Nhft Nhs Uk Download Cfm Doc Docm93jijm4n1416 Pdf Ver 23941
 Evaluation Of The C Diff Quik Chek Complete Assay A New Glutamate
Evaluation Of The C Diff Quik Chek Complete Assay A New Glutamate
Testing Stools For C Diff In Patients After They Have Finished
Http Www Ashnha Com Wp Content Uploads 2018 01 Ashnha Arh C Diff Presentation 1 23 18 Pdf
 Updates In The Management Of Clostridium Difficile For Adults
Updates In The Management Of Clostridium Difficile For Adults
 How To Diagnose Infection Caused By Clostridium Difficile
How To Diagnose Infection Caused By Clostridium Difficile
 Frontiers Lauric Acid Is An Inhibitor Of Clostridium Difficile
Frontiers Lauric Acid Is An Inhibitor Of Clostridium Difficile
 Clostridium Difficile Toxin Gene Detection By Dna Amplification
Clostridium Difficile Toxin Gene Detection By Dna Amplification
 How To Diagnose Infection Caused By Clostridium Difficile
How To Diagnose Infection Caused By Clostridium Difficile
 An Atypical Presentation Of Clostridium Difficile Infection
An Atypical Presentation Of Clostridium Difficile Infection
 Clostridium Difficile Associated Disease Microbewiki
Clostridium Difficile Associated Disease Microbewiki
 Medical Sciences Free Full Text Effectiveness Of A Two Step
Medical Sciences Free Full Text Effectiveness Of A Two Step
 Speaking Of Poopulation The Unofficial University Of Texas
Speaking Of Poopulation The Unofficial University Of Texas
 Clostridium Difficile Toxin A Wikipedia
Clostridium Difficile Toxin A Wikipedia
2010 Ushers In Changes To Clostridium Difficile Testing The
 Clostridium Difficile Toxin Stool Test Blood Tests In London
Clostridium Difficile Toxin Stool Test Blood Tests In London
Https Ipac Canada Org Photos Custom Cjic Cjic Summer2018 Block Pdf
 Misdiagnosis Of C Difficile And Sepsis Results In Patients Death
Misdiagnosis Of C Difficile And Sepsis Results In Patients Death
Stool Sample Clostridium Difficile C Diff
 Clostridium Difficile Associated Diarrhea And Colitis A
Clostridium Difficile Associated Diarrhea And Colitis A
Https Www Gundersenhealth Org App Files Public 6471 Lab Policies Clostridium Difficile Antigen And Toxin Ab Assay Regional Lab 8461 Pdf
 Burden Of Clostridium Difficile Infection In The United States Nejm
Burden Of Clostridium Difficile Infection In The United States Nejm
 Clostridium Difficile Infection Infectious Disease Advisor
Clostridium Difficile Infection Infectious Disease Advisor
 Laboratory Diagnosis Of Clostridium Difficile Insights
Laboratory Diagnosis Of Clostridium Difficile Insights
 C Difficile Toxin B Ql Real Time Pcr Diagnostic Laboratory Of
C Difficile Toxin B Ql Real Time Pcr Diagnostic Laboratory Of
 Clostridium Difficile Pha Infection Control
Clostridium Difficile Pha Infection Control
 Clostridium Difficile Toxin B Elisa Fecal C Difficile Toxin B
Clostridium Difficile Toxin B Elisa Fecal C Difficile Toxin B
Clostridium Difficile Toxin Cdt Induces Formation Of Microtubule
 Iche Journal On Twitter One Of The Most Highly Cited Iche Papers
Iche Journal On Twitter One Of The Most Highly Cited Iche Papers
Emergence Of A Non Sporulating Secondary Phenotype In Clostridium
Emergence Of A Non Sporulating Secondary Phenotype In Clostridium
 C Diff Iccile Should The Treatment B Diff Erent A 2018 Update
C Diff Iccile Should The Treatment B Diff Erent A 2018 Update
Http Www Ashnha Com Wp Content Uploads 2018 01 Ashnha Arh C Diff Presentation 1 23 18 Pdf
 A Laboratory Medicine Best Practices Systematic Review And Meta
A Laboratory Medicine Best Practices Systematic Review And Meta
Https Lecom Edu Content Uploads 2019 02 9 C Difficile Infection How Difficult Is It To Manage Pdf
 Stool Substitute Transplant Therapy For The Eradication Of
Stool Substitute Transplant Therapy For The Eradication Of
 Pin On Jama Patient Information
Pin On Jama Patient Information
Http Www Scacm Org Handoutsfall2017 092917 Scacm Caulfield Pdf
 Clostridium Difficile Colitis Cancer Therapy Advisor
Clostridium Difficile Colitis Cancer Therapy Advisor
 Study Reveals How C Difficile Disrupts The Gut
Study Reveals How C Difficile Disrupts The Gut
 Clostridium Difficile C Diff Foamcast
Clostridium Difficile C Diff Foamcast
 Clostridioides Clostridium Difficile Colitis Practice
Clostridioides Clostridium Difficile Colitis Practice
Stool Sample C Diff Stool Photos
Http Www Ldh La Gov Assets Oph Center Phch Center Ch Infectious Epi Hai Mdro2017 Handouts Commonmdrosinlongtermcare Newest Pdf
 Clostridium Difficile Part One Clinical Overview Quality
Clostridium Difficile Part One Clinical Overview Quality
Clostridium Difficile Associated Diarrhea New Rules For An Old Game
Http Www Med Umich Edu 1info Fhp Practiceguides Inptcdiff C Diff Pdf
 Comparison Of Routine C Difficile Negative Samples Set Of
Comparison Of Routine C Difficile Negative Samples Set Of
Clostridium Difficile Infection A Clinical Review Physician




0 Response to "Formed Stool C Diff"
Post a Comment